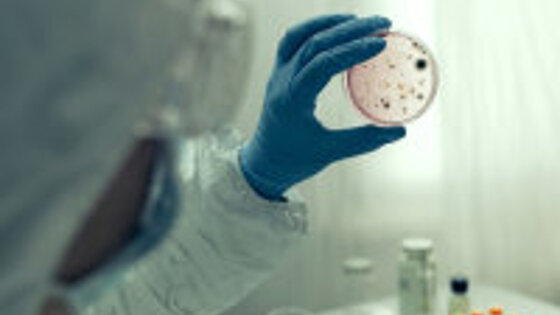
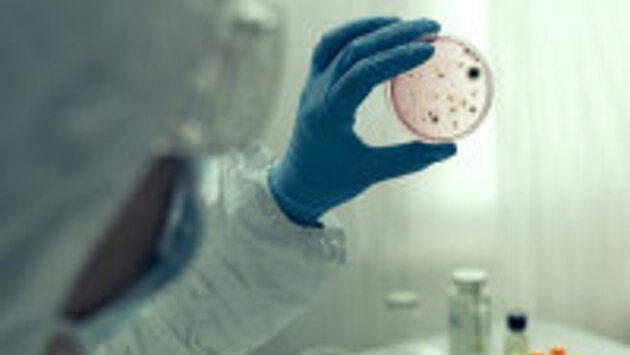

В Киргизии 8 человек госпитализированы с подозрением на сибирскую язву
Восемь человек госпитализированы в Ошскую межобластную объединенную больницу с подозрением на сибирскую язву. Об этом сообщили в министерстве здравоохранения КР. По данным Республиканского центра карантинных и особо опасных инфекций, у одного пациента диагноз подтвердился лабораторно. "Все госпитализированные получают соответствующее лечение, их состояние - удовлетворительное", - отметили в минздраве. В ходе расследования выяснилось, что заболевшие участвовали в забое и разделке зараженной туши коровы. Мясо затем раздали в нескольких селах Ошской области. "Всего выявлено 285 контактных человек. Все они получают необходимые препараты, находятся под наблюдением врачей", - рассказали в министерстве. Создан оперативный штаб по ликвидации очага сибирской язвы. Среди населения проводится санитарно-просветительская работа по профилактике опасного заболевания.